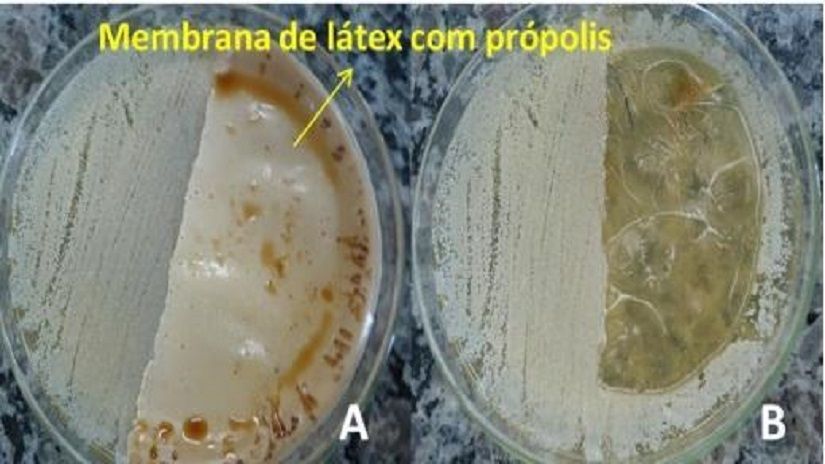
None

INOVAÇÃO EM SAÚDE
Governo de MT investe em pesquisa sobre biomembrana com produtos naturais para reparo de lesões na pele
A biomembrana para úlceras cutâneas contém ingredientes como borracha natural, babosa e própolis
24 de Janeiro de 2022, 09h56
Um projeto de pesquisa financiado pelo Governo do Estado, por meio da Fundação de Amparo à Pesquisa de Mato Grosso (Fapemat), estuda produtos naturais para o reparo e cicatrização de lesões na pele na forma de uma biomembrana vegetal.
A pesquisa é coordenada pela doutora em genética e biologia molecular, Paula Cristina de Souza Souto, do campus universitário do Araguaia (UFMT), Barra do Garças. E desenvolvida pela pesquisadora e doutoranda da UFMT, Loyane Almeida Gamas Sales, vinculada ao Programa de Pós-Graduação em Imunologia e Parasitologia Básica e Aplicada do campus da universidade. A pesquisadora Loyane teve recurso aprovado no Edital Fapemat Nº 009/2021, de dezembro, para o projeto Membrana de borracha natural associada ao extrato de própolis e babosa: avaliação dos efeitos e mecanismos envolvidos no reparo tecidual em modelo de queimadura.
Na medicina, os resultados do estudo mostraram que a biomembrana vegetal é segura como curativo para úlceras cutâneas (feridas). A grande ocorrência mundial de feridas cutâneas, tais como queimaduras, continua alta e com milhares de pessoas sofrendo com sequelas físicas, psicológicas e com as consequências sociais que esse tipo de lesão pode causar.
O projeto intitulado Desenvolvimento e Caracterização de Membranas de Látex de Hevea Brasiliensis e Própolis Scaptotrigona Polysticta para Tratamento de Queimaduras busca produtos naturais de origem animal ou vegetal que possuam propriedades com ação cicatrizante e antimicrobiana em lesões de pele. A pesquisa estuda a preparação de biomembranas de borracha natural (derivada do látex de seringueira) associado à babosa e ao própolis de abelhas sem ferrão, conhecida como Bijuí.
Inovação em tratamento
O tratamento tópico ideal para lesão provocada por queimadura seria aquele que, ao mesmo tempo, controla o crescimento bacteriano, remove o tecido desvitalizado e estimula o crescimento do novo tecido. Até agora, estas três funções não se encontram em um mesmo curativo.
A inovação proposta pela pesquisa foi o desenvolvimento de uma biomembrana com a associação de dois componentes, látex e própolis, típicos da biodiversidade do Estado de Mato Grosso.
Com os resultados da pesquisa foi possível desenvolver biomembranas com características físico-químicas que indicam que elas podem ser utilizadas para o tratamento de queimadura. Em estudos em animais, as biomembranas se mostraram eficientes, pois aceleraram o processo de cicatrização sem a necessidade freqüente de troca do curativo. Além disso, o processo inflamatório, que acontece em todo processo de cicatrização, foi controlado o que indica uma possível cicatrização da pele sem a formação extensiva de cicatrizes.
Tendo em vista a necessidade de tratamentos mais práticos e eficazes no tratamento das queimaduras a membrana de Látex associada ao Própolis apresentou resultados promissores para o uso na medicina.




